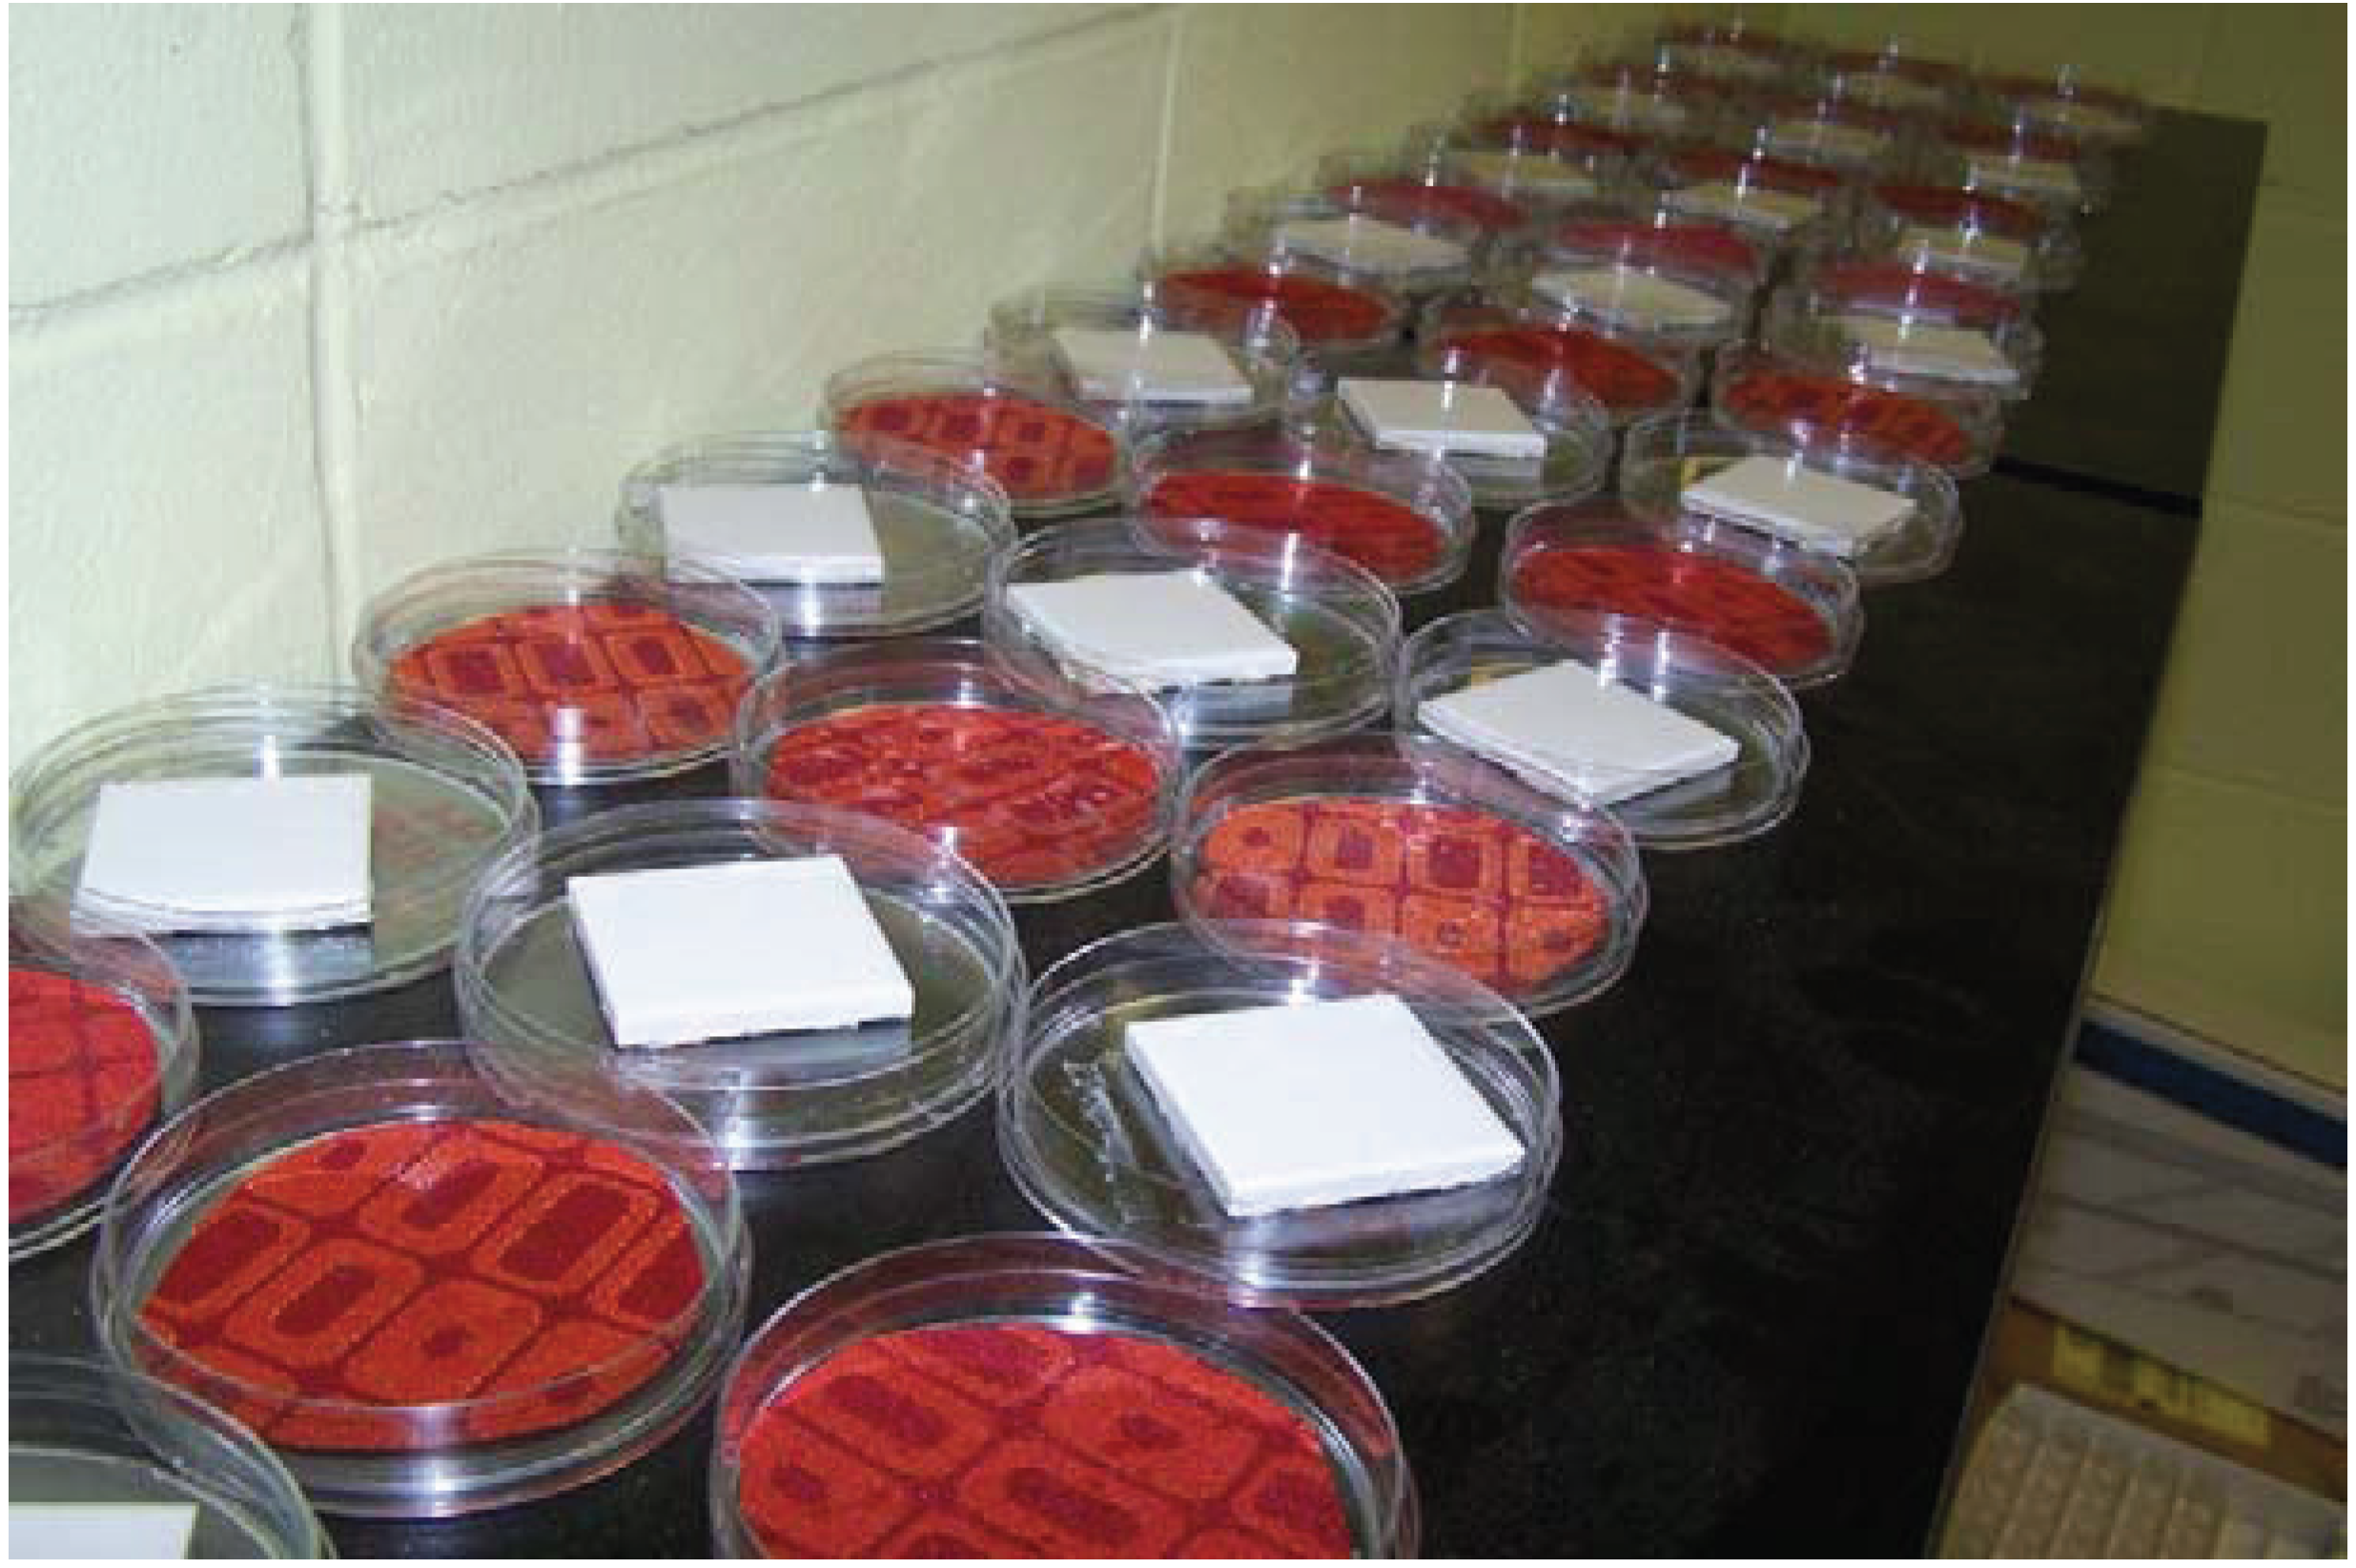

Long-Term Efficacy of Various Natural or “Green” Insecticides against Bed Bugs: A Double-Blind Study
Abstract
:1. Introduction
2. Experimental
2.1. Bed Bugs and Substrates
2.2. Insecticides Tested
| Product | % Active ingredients | How Applied |
|---|---|---|
| Natural, 25(b), or Green Products | ||
| Alpine dust (BASF Corp., Florham Park, NJ, USA) | 95.0% diatomaceous earth | 0.32 oz per 10 ft2 |
| 0.25% dinotefuran | ||
| BBT-2000 (herbal product; primarily cedar and soybean oil) (Swepe-Tite LLC, Tupelo, MS, USA) | 4.0% cedar oil | Per label, “as a fine mist” |
| 1.0% soybean oil | ||
| Cimexa (Rockwell Labs, Kansas City, MO, USA) | 100% amorphous silica gel | 2 oz per 100 ft2 |
| Cimi-Shield Protect (PestBarrier Inc., Carson, CA, USA) | 2.38% soybean oil | Per label, “mix with distilled water, place in never-used spray container, shake vigorously, fan spray from 24 inches, 3 linear ft per second” |
| 13.18% calcium silicate | ||
| 9.14% aluminum sodium silicate | ||
| 7.52% iron oxide | ||
| 7.38% sodium sulfate | ||
| 7.32% magnesium silicate | ||
| 4.20% potassium sulfate | ||
| 2.38% sodium benzoate | ||
| EcoRaider (Reneotech Inc., North Bergen, NJ, USA) | 1.0% geraniol | Per label, “fan spray until wet” |
| 1.0% cedar oil | ||
| 2.0% sodium lauryl sulfate | ||
| Mother Earth D (Whitmire Micro-Gen, Florham Park, NJ, USA) | 100% diatomaceous earth | 0.5 oz per 10 ft2 |
| Traditional Residual Products | ||
| Invader (FMC Corp., Philadelphia, PA, USA) | 1.0% propoxur | Per label, “crawling pests, 1 s spray per spot” |
| Temprid Readyspray (Bayer Corp., Monheim, Germany) | 0.025% cyfluthrin and 0.050% imidacloprid | Per label for spot treatment, “spray 12 to 18 inches from surface, 4 s per 2 ft2” |
| Transport GHP (FMC Corp., Philadelphia, PA, USA) | 22.73% acetamiprid | 0.3 oz per gallon water per 1000 ft2 |
| 27.27% bifenthrin | ||
2.3. Blinding of the Study
2.4. Storage of Treated Substrates
2.5. Exposure of Bed Bugs to Insecticides

2.6. Statistical Analyses
3. Results and Discussion
| Treatment | Substrate | Strain | Mean | Standard Error | Letter Group |
|---|---|---|---|---|---|
| Transport | Hard | Susceptible | 100.00 | 0 | A * |
| Transport | Soft | Susceptible | 100.00 | 0 | A |
| Temprid | Hard | Susceptible | 100.00 | 0 | A |
| Temprid | Soft | Susceptible | 100.00 | 0 | A |
| Invader | Soft | Susceptible | 80.00 | 17.56 | B |
| Cimexa | Soft | Resistant | 50.00 | 2.89 | C |
| BBT-2000 | Hard | Resistant | 46.67 | 17.64 | CD |
| Temprid | Hard | Resistant | 36.67 | 10.93 | CDE |
| Cimexa | Hard | Susceptible | 31.67 | 19.65 | DEF |
| Alpine dust | Hard | Susceptible | 31.67 | 7.27 | DEF |
3.1. Susceptible Strain

3.2. Resistant Strain

4. Conclusions
Acknowledgments
Conflict of Interest
References
- Little, S.E.; West, M.D. Home infestation with cimex lectularius, the common bed bug, affecting both dog and client (abstract No.61). In Proceedings of the Amercian Association Veterinary Parasitologists Annual Meeting, New Orleans, LA, USA, 19–22 July 2008.
- Reinhardt, K.; Siva-Jothy, M.T. Biology of the bed bugs. Ann. Rev. Entomol. 2007, 52, 351–374. [Google Scholar] [CrossRef]
- Ryckman, R.E.; Bently, D.G.; Archbold, E.F. The cimicidae of the americas and oceanic islands, a checklist and bibliography. Bull. Soc. Vector Ecol. 1981, 6, 93–142. [Google Scholar]
- Thomas, I.; Kihiczak, G.G.; Schwartz, R.A. Bedbug bites: A review. Int. J. Dermatol. 2004, 43, 430–459. [Google Scholar] [CrossRef] [PubMed]
- Potter, M.F. The perfect storm: An extension view on bed bugs. Am. Entomol. 2006, 52, 102–104. [Google Scholar]
- Goddard, J.; de Shazo, R.D. Rapid rise in bed bug populations: The need to include them in the differential diagnosis of mysterious skin rashes. South. Med. J. 2008, 101, 854–855. [Google Scholar] [CrossRef] [PubMed]
- Anderson, A.L.; Leffler, K. Bedbug infestations in the news: A picture of an emerging public health problem in the United States. J. Environ. Health 2008, 70, 24–27. [Google Scholar] [PubMed]
- Cleary, C.J.; Buchanan, D. Diagnosis and management of bedbugs: An emerging U.S. Infestation. Nurse Pract. 2004, 29, 46–48. [Google Scholar] [CrossRef] [PubMed]
- Gangloff-Kauffmann, J.; Hollingsworth, C.; Hahn, J.; Hansen, L.; Kard, B.; Waldvogel, M. Bed bugs in America: A pest management industry survey. Am. Entomol. 2006, 52, 105–106. [Google Scholar]
- Bircher, A.J. Systemic immediate allergic reactions to arthropod stings and bites. Dermatology 2005, 210, 119–127. [Google Scholar] [CrossRef] [PubMed]
- Brasch, J.; Schwarz, T. 26-year-old male with urticarial papules. J. Dtsch. Dermatol. Ges. 2006, 4, 1077–1079. [Google Scholar] [CrossRef] [PubMed]
- Churchill, T.P. Urticaria due to bed bug bites. J. Am. Med. Assoc. 1930, 95, 1975–1976. [Google Scholar] [CrossRef]
- Elston, D.M.; Stockwell, S. What’s eating you? Bed bugs. Cutis 2000, 65, 262–264. [Google Scholar] [PubMed]
- Hwang, S.W.; Svoboda, T.J.; de Jong, I.J.; Kabasele, K.J.; Gogosis, E. Bed bug infestations in an urban environment. Emerg. Infect. Dis. 2005, 11, 533–538. [Google Scholar] [CrossRef] [PubMed]
- De Shazo, R.D.; Feldlaufer, M.F.; Mihm, M.C.; Goddard, J. Bullous reactions to bed bug bites reflect cutaneous vasculitis. Am. J. Med. 2012, 125, 688–694. [Google Scholar] [CrossRef] [PubMed]
- Goddard, J.; de Shazo, R.D. Bed bugs (Cimex lectularius) and clinical consequences of their bites. J. Am. Med. Assoc. 2009, 301, 1358–1366. [Google Scholar] [CrossRef]
- Jones, S.C.; Bryant, J. Ineffectiveness of over-the-counter total release foggers against the bed bug. J. Econ. Entomol. 2012, 105, 957–963. [Google Scholar] [CrossRef] [PubMed]
- Singh, N.; Wang, C.; Cooper, R. Natural pesticides for bed bug control: Do they work? Available online: http://www.pctonline.com/pct0313-biopesticides-testing-bed-bugs.aspx (accessed on 18 August 2014).
- Wang, C.; Singh, N.; Cooper, R. Efficacy of an essential oil-based pesticide for controlling bed bug (Cimex lectularius) infestations in apartment buildings. Insects 2014, 5, 849–859. [Google Scholar] [CrossRef]
- Singh, N.; Wang, C.; Cooper, R. Potential of essential oil-based pesticides and detergents for bed bug control. J. Econ. Entomol. 2014, 107. [Google Scholar] [CrossRef]
- SAS. Statistical Analysis Software, Version 9.3, SAS Institute: Raleigh, NC, USA, 2008.
- Abbott, W.S. A method of computing the effectiveness of an insecticide. J. Econ. Entomol. 1925, 18, 265–267. [Google Scholar]
- Doggett, S.L.; Geary, M.J.; Lilly, D.; Russell, R.C. The Efficacy of Diatomaceous Earth Against the Common Bed Bug. In Cimex lectularius; Department of Medical Entomology, ICPMR, Westmead Hospital: Westmead, NSW, Australia, 2008; p. 46. [Google Scholar]
- Gordon, J.R.; Goodman, M.H.; Potter, M.F.; Haynes, K.F. Trouble brewing for insecticides? Available online: http://www.pctonline.com/pct0614-bed-bugs-insecticides-resistance.aspx (accessed on 20 August 2014).
- Gordon, J.R.; Goodman, M.H.; Potter, M.F.; Haynes, K.F. Population variation in and selection for resistance to pyrethroid-neonicotinoid insecticides in the bed bug. Sci. Rep. 2014, 4. [Google Scholar] [CrossRef] [PubMed]
- Potter, M.F.; Haynes, K.F.; Gordon, J.R.; Washburn, L.; Washburn, M.; Hardin, T. Silica gel: A better bed bug dessicant. Available online: http://www.pctonline.com/pct0814-silica-gel-research-bed-bugs.aspx (accessed on 2 September 2014).
- Goddard, J. Laboratory assays of various insecticides against bed bugs and their eggs. J. Entomol. Sci. 2013, 48, 1–5. [Google Scholar]
© 2014 by the authors; licensee MDPI, Basel, Switzerland. This article is an open access article distributed under the terms and conditions of the Creative Commons Attribution license (http://creativecommons.org/licenses/by/4.0/).
Share and Cite
Goddard, J. Long-Term Efficacy of Various Natural or “Green” Insecticides against Bed Bugs: A Double-Blind Study. Insects 2014, 5, 942-951. https://doi.org/10.3390/insects5040942
Goddard J. Long-Term Efficacy of Various Natural or “Green” Insecticides against Bed Bugs: A Double-Blind Study. Insects. 2014; 5(4):942-951. https://doi.org/10.3390/insects5040942
Chicago/Turabian StyleGoddard, Jerome. 2014. "Long-Term Efficacy of Various Natural or “Green” Insecticides against Bed Bugs: A Double-Blind Study" Insects 5, no. 4: 942-951. https://doi.org/10.3390/insects5040942
APA StyleGoddard, J. (2014). Long-Term Efficacy of Various Natural or “Green” Insecticides against Bed Bugs: A Double-Blind Study. Insects, 5(4), 942-951. https://doi.org/10.3390/insects5040942
